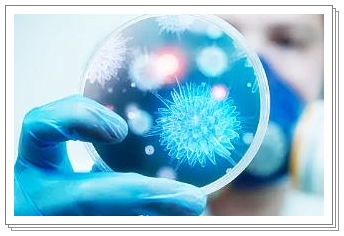

이모저모 여러분들 오늘은 염증수치 낮추는 방법 에 대해서 설명해 드릴까 하는데요. 여러분들 염증이 생겼을때 어떠한 반응이 나타나는지와 염증에는 어떤 종류들이 있는지 알고 계시나요? 염증에는 가볍게 다친 상처부터 감기에 걸렸을때 생기는 염증, 몸 곳곳에 면역력이 떨어져 생기는 염증, 이미 시기가 지난 만성염증 등 다양한 곳에서 염증이 발생하는데요. 대부분 염증은 이럴때 발생합니다. 그럼 염증은 왜 발생하는지? 염증수치 낮추는 방법은 어떤것들이 있는지 한번 시작해 볼까요?
염증이 생기는 이유

염증은 우리 몸에 손상을 받았을 때 방어적인 반응으로 치료해달라고 도움을 구하는 신호입니다. 대부분 염증은 피부의 상처로 인해 바이러스나, 세균이 침투했을때 스스로를 지키기 위한 자연적인 현상인데요 통증, 발열, 부종을 동반하기도 하며, 호흡기 염증으로는 중이염, 비염, 기관지염 등이 있으며, 내부속 장기에 염증으로는 위염, 간염, 췌장염, 장염, 식도염 등 다양한 병명이 존재합니다. 이렇듯 염증은 다양한 곳에 발생을 하여 이렇게 관리를 하는것이 좋은데요. 평소의 생활습관으로도 충분히 염증을 관리할수 있습니다.
염증수치 낮추는 방법
1. 설탕등 액상과당이 많이 들은 식품을 피하자.
첫번째로 설탕 등 액상과당이 많이 들은 식품은 피하시는게 좋은데요. 그 이유는 염증을 활성화 시키는 물질인 사이토카인이 많이 들어있기 때문입니다. 그렇기에 평소에 물엿이나 인스턴트로 된 너무 단 음식은 삼가하여 주시기 바라며, 특히 음료수는 마시기 전에 성분을 확인하시어 골라 드시는것도 하나의 방법이 될 것 같습니다.
2. 붉은색이 띄는 육류를 줄이자.



붉은색이 띠는 육류를 많이 드시는 것 또한 염증 수치를 높이는 하나의 주범이 되는데요. 그 이유는 붉은 고기에는 포화지방이 다량 함유가 되어 있습니다. 이는 체내의 염증이 있을 경우 그 염증 수치를 높여 염증이 있을 경우 과도한 육류 섭취는 피하도록 하며 단백질이 풍부한 식품으로 대체하여 골고루 드셔 주시기 바랍니다.
3. 규칙적인 운동하기



규칙적인 운동을 하는것은 먹는 것만큼 매우 중요합니다. 하루에 30분씩 걷는 것만으로도 우리 몸의 있는 세포들이 활성화 되며, 스트레스 해소등 염증 수치가 낮아지는데요. 그렇기에 귀찮더라도 하루에 30분씩은 유산소 운동으로 우리몸의 신진대사를 활발하게 만들어 주시기 바랍니다.
4. 염증에 좋은 오메가 3 섭취하기
오메가 3 는 우리몸에 아주 좋은 불포화 지방산 입니다. 특히 생선 , 달걀 등 에는 몸에 좋은 불포화 지방산이 풍부하게 들어가 있어 혈중 중성지질과 혈행을 개선하여 염증 수치를 낮춰주는데 매우 큰 도움이 된다고 합니다. 그렇기에 음식으로 섭취를 하지 못한다면 오메가 3 만 되어 있는 제품을 구입하여 드셔주어도 몸에 큰 도움이 됩니다.
5. 생강 먹기



생강은 몸을 따스하게 만들어주는 성분이 있는데요. 이는 염증 완화에도 매우 탁월합니다. 그 이유는 생강에는 진저롤이라는 알싸한 맛을 내는 성분이 염증 유발 효소를 억제시켜주며, 이부프로펜 과 같은 염증 완화 약제 성분 과 거의 흡사한 효과를 낸다고 합니다. 그렇기에 쓴 생강이지만 염증 완화를 원한다면 가끔 차로 해서 드셔 보시기 바랍니다.
6. 식용유의 과다 섭취를 피하자.



식용유 또한 과다하게 섭취를 하는 것은 피하셔야 하는데요. 특히, 옥수수나 콩으로 제조하는 식용유 같은 경우에는 기름에 오메가 6지방산이 과도하게 들어가 있습니다. 그렇기에 오메가 6지방산의 섭취는 적정량을 드셨을 경우에는 도움이 되지만 과도하게 섭취하게 되면 생성된 호르몬이 염증을 유발시키며, 악화 시킬수 있기 때문에 조심하셔야 합니다.
7. 카테킨 성분이 들은 차를 자주 음용해 주세요.



염증이 생기는 이유는 앞에서 말했다시피 우리 몸속에 활성산소가 많게 되면 염증을 일으키는 사이토카인이 다량 분비가 되기 때문에 수치가 올라가게 됩니다. 그렇기에 이를 줄여주시는 것이 좋은데요. 이 중 카테킨 성분이 들은 차를 마셔주실 경우에 몸 속에 쌓인 활성산소를 배출해 내 염증 수치를 낮추는데 도움이 된다고 합니다. 예 녹차 홍차 등
8. 식이섬유가 풍부한 식품 및 유산균을 드셔 주세요.
대장에는 우리몸의 면역체계에 영향을 주는 유익균과 유해균이 있습니다. 그렇기에 유해균이 많게 되면 몸의 곳곳에서 염증이 일어나게 되는데요. 그래서 몸의 유익균을 늘려주시는것이 좋습니다. 예를 들어 식이섬유가 풍부한 식품을 자주 드셔 준다거나 , 유산균을 구입하여 드셔 주어 장내의 환경을 좋게 만들어 주도록 노력합시다. 단, 유산균은 6개월이 지난 후 바꿔주시는게 좋으며, 본인에게 맞는것을 꼭 찾으시길 바랍니다.
이모저모 여러분들 잘보셨나요? 오늘은 이렇게 염증수치 낮추는 방법 에 대해서 알아보았는데요. 염증수치 낮추는 것은 일상생활에서 생활습관으로도 충분히 수치를 낮출수 있는것 같은데요. 여러분들도 위해 있는 생활습관으로 염증수치 낮추어 건강한 삶 행복한 삶 사시길 바라겠습니다. 오늘도 저의 포스팅을 읽어주셔서 감사드리며, 저는 다음에 더 좋은내용으로 찾아뵙도록 하겠습니다.
'건강정보' 카테고리의 다른 글
| 피크노제놀 효능, 복용법 알아보기 (0) | 2024.05.09 |
|---|---|
| 크릴오일 효능 10가지, 부작용 알아보기 (0) | 2024.05.09 |
| 코골이 줄이는 방법 4가지 (2) | 2024.04.30 |
| 복식호흡하는 방법 3가지 (0) | 2024.04.29 |
| 기초대사량 늘리는 방법 10가지 (2) | 2024.04.29 |